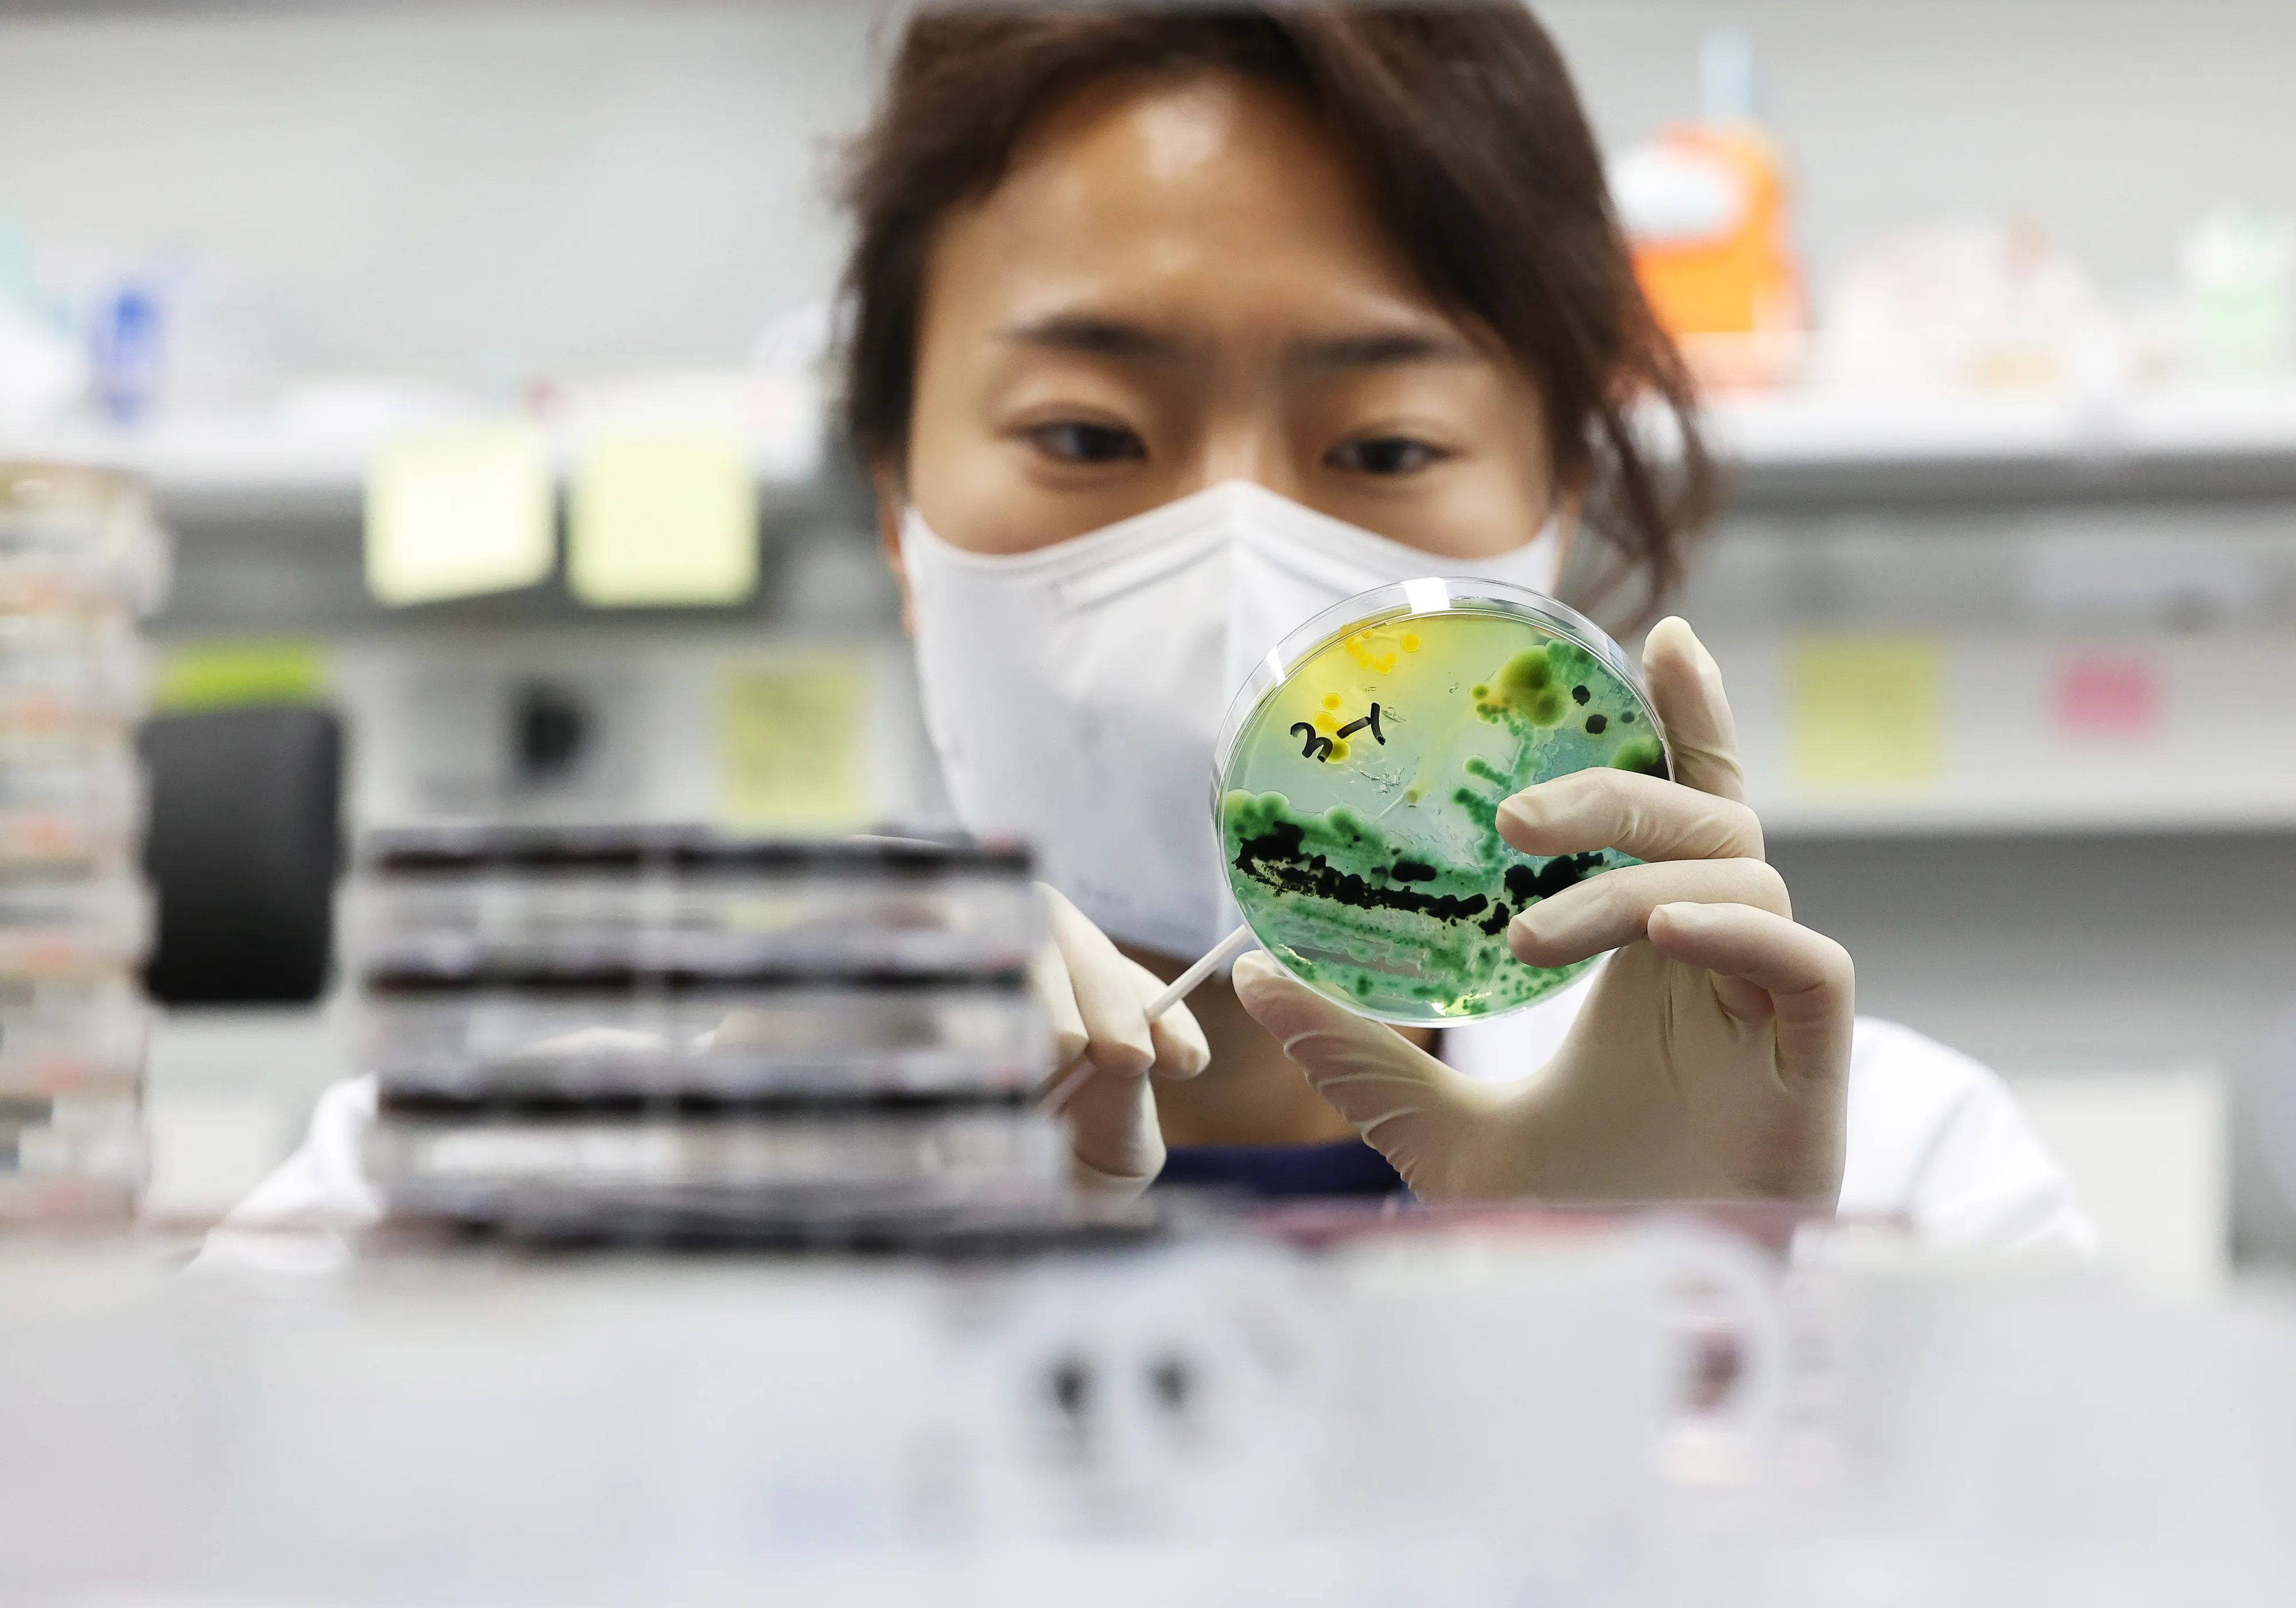

“간·당뇨 환자에 치명적”…치사율 50% ‘이것’ 서해안서 나왔다
하승연 기자
입력 2025 04 23 19:09
수정 2025 04 23 19:09

고운 모래가 깔려 있고 경사가 완만한데다 수심도 얕은 게 특징인 ‘만리포 해수욕장’은 서해안 3대 해변으로 꼽힌다. 태안군 제공
해수 온도가 상승하는 여름철에 집중적으로 발생하는 감염병인 비브리오패혈증균(Vibrio vulnificus)이 올해 처음으로 서해안에서 검출됐다.
23일 전북특별자치도 보건환경연구원에 따르면 지난 14일 채취한 해수에서 처음으로 비브리오패혈증균이 검출됐다. 지난해 23일 검출된 것과 비교하면 첫 검출이 1주 정도 앞당겨진 상황이다.
이는 지구온난화 영향으로 분석되고 있다. 비브리오패혈증균이 해수 온도가 18도 이상일 때 잘 증식하는 특성 때문에 해마다 검출 시기가 빨라지는 것으로 판단된다.
비브리오패혈증은 해수 온도가 상승하는 여름철에 집중적으로 발생하는 감염병으로, 서해안 지역 해수와 갯벌, 어패류에서 주로 검출된다.
주로 해산물을 덜 익혀 먹거나 상처 난 피부에 오염된 바닷물이 접촉했을 때 감염되며, 감염될 경우 치사율이 50%에 달하며 간질환 환자, 당뇨 환자 등 기저질환을 가진 고위험군에는 특히 치명적이다.
비브리오패혈증이 의심되면 즉시 신속하게 치료하는 것이 중요하지만, 신속하게 치료했을 경우라도 저혈압이 발생하면 90% 이상으로 증가하기 때문에 주의해야 한다.
연구원은 군산, 고창, 부안 등 서해안 지역을 중심으로 4월부터 10월까지 매주 비브리오 유행예측 감시사업을 실시하고 있다.
22일 오후 경기도 수원시 권선구 경기도보건환경연구원에서 연구원들이 채취한 바닷물에서 비브리오패혈증균 선택배양작업을 시연하고 있다. 질병관리청은 올해 첫 비브리오패혈증 사망 환자가 발생했다며 어패류를 충분히 익혀 먹으라고 22일 당부했다. 2024.5.22 연합뉴스
비브리오패혈증을 예방하기 위해서는 간이 안 좋거나 면역이 저하된 사람과 같은 고위험군은 어패류를 날것으로 먹는 것을 피하고, 피부에 상처가 있는 사람은 가급적 바닷물과 접촉하지 않도록 해야 한다.
만약 바닷물과 접촉하였을 경우 깨끗한 물과 비누로 노출 부위를 씻어 내야 하며, 여름철에 어패류는 5℃ 이하의 저온 상태로 저장하고, 흐르는 물에 깨끗이 씻은 후 85℃ 이상으로 가열 처리해 섭취해야 한다.
조개류를 끓여서 요리할 때는 껍질이 열린 후 5분 이상 끓여야 하며, 어패류를 요리한 도마, 칼 등의 조리도구를 소독해서 사용하는 것이 중요하다.
전북보건환경연구원 측은 “비브리오패혈증은 치사율이 매우 높은 질환으로 기저질환이 있는 고위험군의 경우 더욱 주의해야 한다”고 전했다.
하승연 기자
ⓒ 트윅, 무단 전재 및 재배포 금지

















































